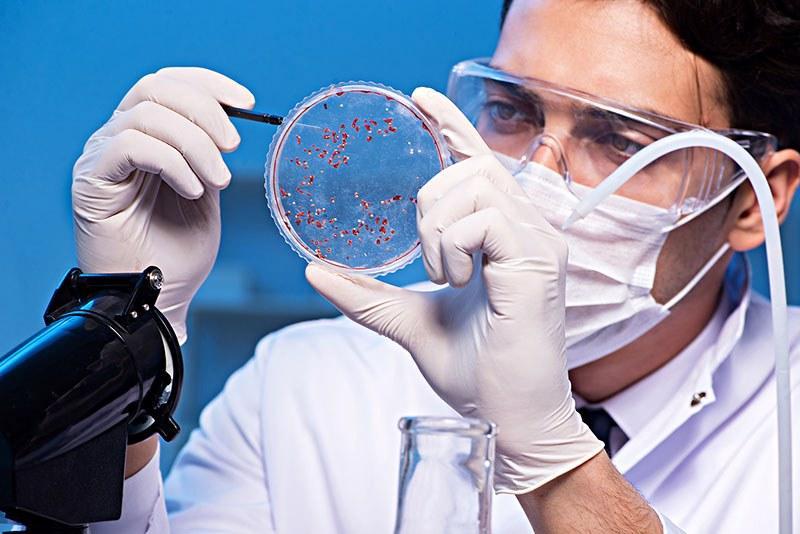

顛覆!科學家首次證實,老年癡呆症具有傳染性,一類人容易中招
流感可以人傳人,新冠可以人傳人,老年癡呆症竟然也可以人傳人!
就在兩天前,倫敦大學學院John Colinge團隊在權威雜誌《自然·醫學》發表了新成果。他們首次報告了阿爾茨海默病在人與人之間傳播的明確證據。
在此之前,這個團隊就曾發現阿爾茨海默症在小鼠身體中出現了傳染現象,這次更是直接找到阿爾茨海默症可以傳染的有力證據。
這個結果對業界來說,是轟動;對普通人來說,是恐慌——如果阿爾茨海默症可以“人傳人”,那該怎麼預防?

一、震撼!早就有人懷疑老年癡呆能傳染!
阿爾茨海默症被證明爲“人傳人”的過程,頗爲曲折。
1956年,身材矮小的人治療長高,需要用到用去世者腦垂體中提取出來的生長激素,這種激素是屍源性人生長激素(c-hGH)。但卻有一部分經過c-hGH治療的人患上克雅病——一種由錯誤摺疊的PrP蛋白,也就是朊病毒引起的,朊病毒在牛身上,會引發衆所周知的“瘋牛病”。
這說明朊病毒混在生長激素裏,被注射進患者的血液,然後入侵大腦。僅僅少量的朊病毒就能引起正常摺疊的朊蛋白轉爲錯誤結構,並不斷聚集,持續地自我複製,最後擴散到整個腦部,導致死亡。

而科學家是如何從這一現象中發現阿爾茨海默症也有可能“人傳人”的呢?
2015年,一篇發表在《自然》的研究表示,8位死於克雅氏病的死者腦中發現了β澱粉樣蛋白(阿爾茨海默病的生物標誌物特徵),能使其他β澱粉樣蛋白錯誤摺疊並沉降在大腦裏,形成具有神經毒性的斑塊。
而這種阿爾茨海默病中的標誌性蛋白,擁有類似於朊病毒的傳播機制,它們能誘導其他β澱粉樣蛋白以錯誤結構聚集,持續自我複製,從大腦深處向外腐蝕,直到令整個大腦的神經元死亡。
尤其當研究人員在其他朊病毒感染患者的腦內並沒有找到β澱粉樣蛋白時,他們更加懷疑β澱粉樣蛋白跟朊病毒一樣,可以隨着注射器一起進入人體,然後發展出阿爾茨海默症。
於是一時間,關於阿爾茨海默病的“人傳人”報道熱火朝天。

但是,這個假說,後來又被倫敦大學學院英國癡呆症研究所巴爾特·德斯特魯帕教授的團隊推翻了,教授表示,我們沒有任何神經退行性疾病(克雅氏病除外)能通過人-人途徑傳播的確鑿證據,而且8個樣本量太少無法提供充足的支撐,“阿爾茨海默症人傳人”的說法被視爲無稽之談。

二、確認!阿爾茨海默症真的會傳染
但就在2017-2022年間,英國國家朊病毒診所相繼發現了8例高度懷疑阿爾茨海默病的患者。他們很特別,在發病因素上不屬於家族性,也不屬於散發性。
唯一的共同點就是因爲生長激素缺乏,他們在童年時期都接受過相同治療:
人屍體垂體源性生長激素(c-hGH)補充治療。
這項已經被禁止使用幾十年的技術,不僅使病人患上克雅病,還可能傳播β澱粉樣蛋白,導致阿爾茨海默病。
可以說,人爲導致的悲劇貫穿了患者的一生。這一點跟“阿爾茨海默病人傳人”的結論同樣令人震撼。

不過大家對於“阿爾茨海默症人傳人”的說法不必過於恐慌,該人傳人不是的機制並非像普通流行病毒傳染一樣,況且也沒有任何確切證據表明阿爾茨海默症在日常生活中會傳播,而引發該爭議的生長激素療法已經在全球範圍內禁止。
反而目前有不少科學家認爲,“阿爾茨海默人傳人”的說法,更有利於醫學界攻克阿爾茨海默症:
雖然這裏報告的新型阿爾茨海默氏症引起了極大的科學興趣,因爲它揭示了一種新的疾病傳播方式,但我們沒有理由對此感到恐懼,因爲這種疾病的致病方式早在 40 多年前就被制止了。以這種方式在人腦之間傳播疾病的情況再也不會發生了。
科爾哈斯表示,沒有證據表明,澱粉樣蛋白可以通過任何其他途徑,如日常活動或常規醫療程序傳播。但這項研究揭示了更多關於澱粉樣蛋白碎片如何在大腦內擴散的信息,爲阿爾茨海默氏症如何發展提供了進一步的線索,也爲未來的治療提供了潛在的新目標。
三、長輩出現10個信號,或許說明被阿爾茨海默症盯上了
截至2015年,我國已有超過700萬名癡呆患者,居世界首位。到2030年,這一數字可能會超過1500萬!
當阿爾茨海默症盯上長輩時,會有10個信號,千萬別大意:
(1)容易忘記前一刻發生的事,比如無意識地重複多喫放鹽。
(2)非常健忘,忘記的事情很難想起來,還容易反覆詢問同一件事。
(3)時間概念以及方向感下降甚至缺失,在自己熟悉的生活區域迷路。
(4)記憶力以及學習能力下降,即使是日常很簡單的知識也容易忘記。

(5)屋內雜亂,喜歡收廢品或者隨處亂放自己的物品。
(6)識別能力下降,容易上當受騙被欺詐。
(7)情緒大變,情緒容易有異常的起伏,疑神疑鬼。
(8)在短時間內情緒起伏巨大,上一秒開懷大笑,下一秒淚流滿面。
(9)抽象思維下降,難以記住數字,忘記手機號、密碼等
(10)活力降低,彷彿對生活失去興趣,主動性下降,變得懶惰。

2、做到2件事,阿爾茲海默症風險降低20%
阿爾茨海默病循證預防國際指南顯示,做到以下內容,有望延緩或預防40%阿爾茨海默病的發生:
其一,保持良好的生活方式。中青年要注意保持身材,避免過於肥胖,老年人要保持充足營養,避免過瘦;遠離二手菸,自身也避免吸菸;要堅持定期運動,不要整日玩手機。
其二,定期檢查身體,避免幾類疾病。避免患上糖尿病與高血壓;保護好自己的頭部,不要擠壓頭部,避免撞傷頭部;在精神上,要保持心情愉悅,避免長期過度緊張,要找合適的方法釋放壓力。
參考資料:
[1]《阿爾茨海默病不可怕,預防有辦法 | 科普時間》.健康中國 .2023-09-25
[2]《<自然·醫學>重磅:發現阿爾茨海默病“人傳人”的證據!屍檢報告表明,醫源性β澱粉樣蛋白或可引起阿爾茨海默病》.奇點網 .2024-01-30
[3]《顛覆認知!阿爾茨海默病能傳染?已發現 8 例患者 》.丁香園. 2023-10-14

















